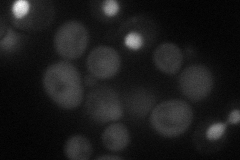
YML054C
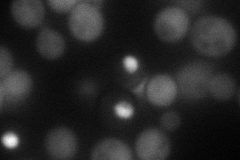
YML054C
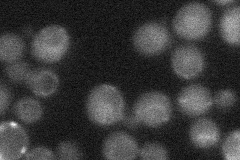
YML054C
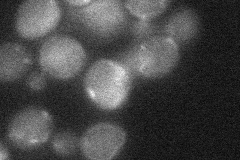
YML054C

View description
Cytochrome b2 (L-lactate cytochrome-c oxidoreductase), component of the mitochondrial intermembrane space, required for lactate utilization; expression is repressed by glucose and anaerobic conditions
Localization:
Intensity:
Fold change:
Significance:
-
C’ GFP library in SD

below threshold17.23 -
N' NOP1pr-GFP in SD
cytosol,nucleus47.2518 -
N' TEF2pr-mCherry in SD
cytosol,nucleus54.5196 -
N' NATIVEpr-GFP in SD
below threshold21.795 -
N' TEF2pr-VC and Cyto-VN in SD
below threshold24.669 -
C’ GFP library in SD+DTT

cytosol19.921.15No -
C’ GFP library in SD+H2O2

cytosol17.961.04No -
C’ GFP library in Starvation Media

mitochondria20.051.16No -
C’ GFP library on the background of Pup2-DaMP

below threshold -
C’ GFP library on the background of CCT mutant

below threshold22.36441.29759No
